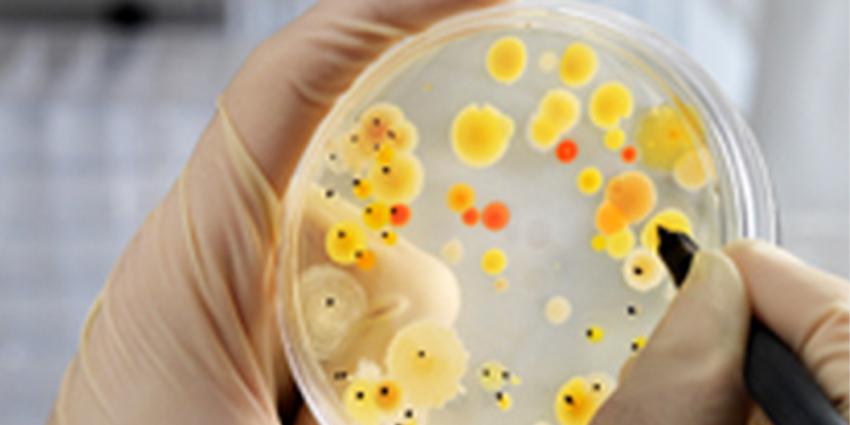
WHO waarschuwt voor twaalf bacteriën

De Nederlandse Voedsel en Waren Autoriteit (NVWA) waarschuwt vrijdag voor de aanwezigheid van de Escherichia Coli (E. coli) bacterie in rauwmelkse Franse kaas
De Nederlandse Voedsel en Waren Autoriteit (NVWA) waarschuwt vrijdag voor de aanwezigheid van de Escherichia Coli (E. coli) bacterie in rauwmelkse Franse kaas

In het Universitair Medisch Centrum Groningen (UMCG) doen orthodontisten onderzoek naar de mogelijkheid om beugels en tandprotheses te maken van bacteriedodend

Uit een proefschrift, waar Heleen de Man 8 april op promoveert aan de Universiteit Utrecht, blijkt dat water op straat en water in bedriegertjes of fonteinen

Albert Heijn (AH) heeft salami die besmet is met de E. coli STEC-bacterie, uit de schappen gehaald. Dit meldt AH maandag.

DEEN Supermarkten haalt met onmiddellijke ingang de bakjes Deen knoflooksaus terug. Dit meldt de Nederlandse Voedsel- en Warenautoriteit (NVWA) vrijdag.

Het Westfriesgasthuis onderzoekt bijna 300 (oud) patiënten op de VRE-bacterie. Dit maakt het ziekenhuis maandagmiddag bekend.

In Limburg is afgelopen zomer een patiënt besmet geraakt met tularemie, ook wel bekend als konijnenkoorts. Dit meldt het Rijksinstituut voor Volksgezondheid en

Bij inmiddels 31 patiënten van Máxima Medisch Centrum (MMC) in Veldhoven is de VRE bacterie aangetroffen. Dit meldt het MMC maandag.

Het Deventer Ziekenhuis gaat de schoonmaak van isolatiekamers intensiveren en versterkt aandacht vragen voor hygiëne.